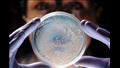
التغير المناخي يهدد أكثر من 900 نوع من الميكروبات

التغير المناخي يهدد أكثر من 900 نوع من الميكروبات بالاختفاء
كتب : مصراوي
التغير المناخي يهدد أكثر من 900 نوع من الميكروبات
أعلن باحثون عن وجود 968 نوعًا من الكائنات الدقيقة، الموجودة تحت أنهار التبت الجليدية المتطرفة.
وأفاد الفريق البحثي، أن أسطح الجليد تدعم وجود الكائنات الدقيقة، بما في ذلك البكتيريا والطحالب والفطريات، وغيرها من المكيروبات، مشيرين إلى أنها تتكيف مع الظروف القاسية والمساهمة في العمليات البيئية الحيوبة، وفقًا لموقع "سكاي نيوز" عربية.
وذكر الموقع أن أكثر من 80 % من الأنهار الجليدية، التي تأثرت في التغير بالمناخ كثيرًا.
وبالنسبة للعلماء ليس المهم فقط معرفة نوع الميكروبات الموجودة في تلك المنطقة، إنما اللحاق بملاحظتها وتسجيلها قبل أن يؤدي التغير المناخي إلى اختفائها على الإطلاق.
وأخذ الباحثون عينات من الثلج والجليد والغبار من 21 نهرا جليديا في التبت بين عامي 2016 و2020.
وتعتبر نتائج الدراسة قاعدة بيانات ومنصة لأرشفة وتحليل ومقارنة الميكروبيوم الجليدي على مستوى الجينوم والجينات، ولذلك أهمية كبيرة وسط مايتعرض له النظام البيئي الجليدي من تهديد بارتفاع نسب الاحترار.